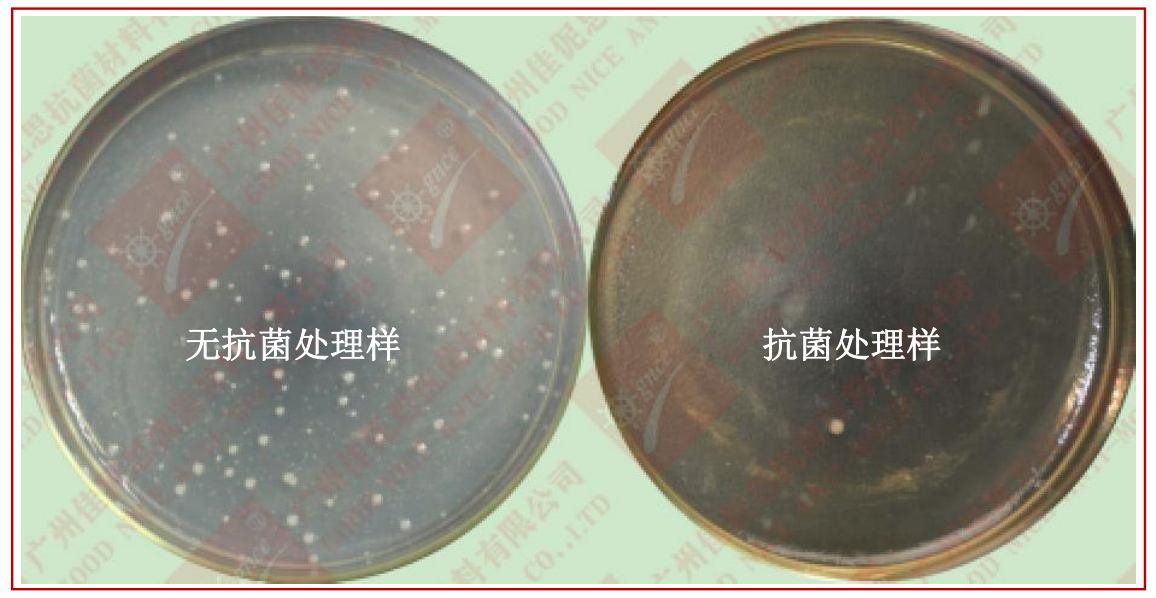
1677037798535.png image.png

概述
抗菌剂 AEM5700-Z,是具有纳米抗菌成分的抗菌剂,把具有抗菌作用的抗菌剂以稳定的形态均匀地分布到纳米成分的结构中,是具有抗菌作用的超微细粉末。其具有较高的耐温、安全性,对细菌具有长效杀菌作用。且其添加在橡塑、化纤、塑料、硅胶中不会发生变色、迁移流失现象,其粒径分布均匀、超细,可适用于多种材料的添加抗菌加工。
1.广谱抗菌性:银离子抗菌剂对多种细菌都具明显抗菌效果。
2.抗菌效率高:添加有合适量银离子的塑料,对金黄色葡萄球菌、白色念珠菌、大肠杆菌等多种病菌的抗菌率可达99%。
3.效果持久、耐候性好:一般抗菌剂易逐渐分解,导致抗菌效率持续下降。银离子抗菌剂可保持持久的抗菌效果。
4.热稳定性好,耐高温,不易变色。
5.良好的相容和分散均匀性,不影响颜色和透明度,不易流失。
6.不改变塑料原有加工工艺,也不影响产品品质、功能。
7.环保:有效成份已由 SGS、疾控中心等权威部门认证。
适用范围
◎塑料制品:PP、PS、PET、AS、PE、PC、ABS 等
◎化学纤维制品、纺织
◎陶瓷
◎涂料
使用方法
1.本产品可直接添加使用。
2.使用量为 1%-1.5%,我司可根据用途提供技术支持。以下为一种注塑的工业流程图:

温馨提示
1.使用时请勿用手直接接触,尤其是不能接触到眼睛或鼻子,操作过程中请佩戴口罩和橡胶手套。
2.若抗菌剂不慎接触皮肤,请及时用肥皂水彻底清洗 5 分钟。
3.初次使用请根据产品的颜色、透明度、相容性等是否符合要求进行加工工艺测试,我司可提供技术支持。
使用效果
-
金属抗菌剂
点击收藏 查看详情 -
银离子抗菌剂
点击收藏 查看详情 -
ABS抗菌母粒
点击收藏 查看详情 -
银离子洗衣液抗菌剂点击收藏 查看详情
-
锌类抗菌剂点击收藏 查看详情
-
固体硅胶抗菌膏点击收藏 查看详情






